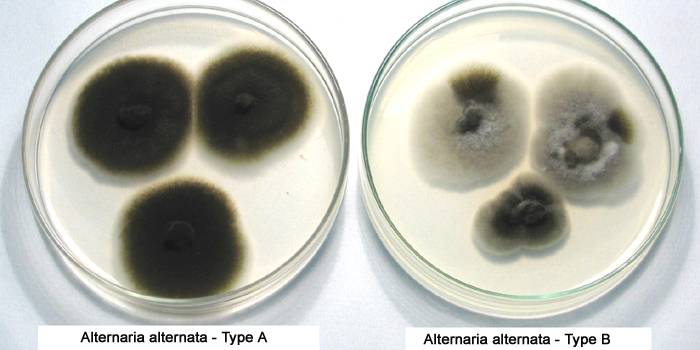

Ako sa zbaviť čiernych plesní na stenách a strope
Huba, ktorá sa rozmnožuje v kolóniách, nielen kazí všetko okolo, ale je nebezpečná aj pre ľudské zdravie, najmä pri oslabenej imunite. Hlavnými biotopmi huby sú vlhké a teplé miestnosti so slabým vetraním.
Druhy plesní
Najbežnejšie druhy plesní v domoch a bytoch: Aspergillus black, Aspergillum fuming, Alternaria alternata. Každý druh má svoje vlastné charakteristiky, od ktorých závisí výber metód kontroly kolónie húb.
Aspergillus čierny

Aspergillus niger je najnebezpečnejším druhom. Propagované vo vlhkých a teplých izbách: kúpeľne, kuchyne, bazény. Huby môžu žiť v práčke, zvlhčovači alebo klimatizácii. Toto je ten druh, ktorý robí švy okolo vane čiernou, medzi dlaždicami na stenách, šíri škvrny na strope, je ťažké sa jej zbaviť.
Osoba, ktorá dýcha v sporách huby, riskuje astmu, meningitídu, zápal pľúc.
Zvýšená toxicita spór, rýchlosť šírenia v celom byte sú charakteristickými znakmi čierneho Aspergillus.
Fajčenie na aspergill

Aspergillus fumigatus ničí červené krvinky, potláča rezistenciu tela voči infekciám a spôsobuje alergie. Zdraví ľudia so silnou imunitou sa toho neboja. Môžu vdychovať veľké množstvo spór bez poškodenia zdravia.
Fajčenie aspergillu sa vyskytuje na potravinách, ovplyvňuje zeleninu, ovocie, chlieb, navonok je namodralý povlak. Znáša vysoké teploty až do + 53 ° C.
Alternaria Alternata
Alternaria alternata vyzerá ako čierna alebo sivá škvrna s olivovým odtieňom. Vyskytuje sa na rozmaznanej hnilobe zeleniny, ovocia, chleba, plodín, zakoreňuje látky, môže byť obsiahnutý v domácom prachu. Lepšie sa množia na strome. Prepravuje sa vo vnútri, vonku za suchého veterného počasia.
Toxíny spór huby sú nebezpečné - môžu otráviť jedlo. Usadzujú sa v dýchacích orgánoch, spôsobujú ťažkú intoxikáciu tela, bronchiálnu astmu, dermatitídu, alergie.
Čo je to nebezpečná pleseň

Spóry húb ľahko rozptýlia vzduchom, usadia sa na rôznych povrchoch a preniknú do dýchacích orgánov ľudí. Toxíny vylučované týmito spórami nepriaznivo ovplyvňujú zdravie a môžu spôsobiť:
-
alergia na chlad, prach;
- pocit dusnosti;
- bolesť hrdla;
- nádcha
- kašeľ;
- bolesť hlavy;
- ťažkosti s dýchaním.
- kožná dermatitída;
- bronchiálna astma;
- meningitída;
- zápal pľúc;
- nádcha;
- všeobecné zníženie imunity;
- objavenie sa papilómov;
- onkologické ochorenia.
Z akej formy sa objaví na stenách

Príčiny výskytu huby v dome:
-
Vlhkosť spolu s vysokou teplotou vzduchu od +18 do +25 ° С.
- Nízka ventilácia bytu, v dôsledku toho nedostatočná cirkulácia vzduchu.
- Nesprávna prevádzka plastových okien môže spôsobiť kondenzáciu, tlmenie sklonu okien a zvýšenie celkovej vlhkosti vzduchu v miestnosti.
- Sadrokartón, ktorý sa dobre vstrebáva, dlhodobo zadržiava vlhkosť, je priaznivým prostredím na šírenie kolónií húb.
Ako sa zbaviť plesní v byte

Činnosti pred a po spracovaní:
-
Pred spracovaním odstráňte z priestorov deti a domáce zvieratá.
- Z miestnosti vyberte všetko, čo je možné, zvyšok zakryte niekoľkými vrstvami filmu.
- Pri odstraňovaní plesne používajte gumové rukavice, ochranné okuliare, respirátor, aby nevdychoval vzduch naplnený spórami.
- Po použití ich vyhoďte, aby nedošlo k šíreniu spór húb.
- Po spracovaní nezabudnite vetrať miestnosť.
- Nepoužívajte ventilátor. S prúdom vzduchu sa spóry huby okamžite rozšíria po celej miestnosti.
- Nepoužívajte vysávač. Huby vo vnútri dokonale prežijú, môžu sa šíriť cez vyfukovací otvor.
Špecializované služby

Profesionáli sú priťahovaní, keď:
-
Kolónia huby sa rozprestiera na ploche viac ako 3 metre štvorcové.
- Pleseň prenikla hlboko do vykurovacieho a vetracieho systému.
- Vzhľad huby súvisí s plnením odpadových vôd.
- Zdravotné problémy spôsobené plesňou v dome.
- S plesňou sa nedokážem vyrovnať sám.
Spôsoby spracovania v byte:
-
Horúca hmla. Jedná sa o špeciálnu technológiu na ohrev dezinfekčných prostriedkov, ktoré sa rozdeľujú na mikročastice - fumigácia. Jedy môžu preniknúť na najmenšie trhliny a zničiť až 99% plesňových spór.
- Metóda studenej hmly. Fumigácia bez zahrievania dezinfekčných prostriedkov.
- Liečba tekutými insekticídmi. Na odstránenie huby sa vykonáva chemické ošetrenie za mokra.
- Plynovania. Miestnosť je naplnená plynom, ktorý blokuje šírenie plesňových spór. Potom je forma zničená.
UV lampa

UV lampa sa vyrovná s úlohou zničiť nebezpečnú kolóniu húb. Ultrafialové lúče úspešne ničia huby, ničia spóry. Keď pleseň preniká hlboko do stien, baktericídne lúče ju nepomôžu odstrániť.
Aby ste sa úplne zbavili problému, musíte vyčistiť steny do betónu a až potom vykonajte dezinfekčný postup pomocou UV lampy.
Kremeň vyžaduje dodržiavanie určitých pravidiel a bezpečnostných opatrení:
-
Odstráňte čerstvé kvety z areálu, akvárium s rybami, zvieratami. UV lúče môžu ničiť nielen baktérie, huby, ale aj celý život v okolí.
- Na popálenie sietnice používajte špeciálne okuliare.
- Svietidlo zapnite každý deň po dobu 30-40 minút.
- Po dezinfekcii byt vetrajte.
Profesionálne nástroje

Aby ste sa zbavili plesní so silným znečistením a prenikli hlboko do stien a stropov, je lepšie zvoliť profesionálne prípravky:
-
Sprej "Mellerud". Vhodný na ničenie všetkých druhov plesní v obkladoch kúpeľní, bazénov. Môže byť použitý na kameň, drevené povrchy, tapety. Nemusia byť špeciálne pripravené. Aby ste sa zbavili huby, produkt sa jednoducho nastrieka na plochu, ktorá sa má vyčistiť, zo vzdialenosti 5 cm. Nie je potrebné ju umyť, netvorí škvrny, lepkavý povlak. Akčný čas - 20 minút. Stojí to 394 s. na 500 ml.
- Sprej "Astonish". Používa sa na čistenie sprchovacích kabín, vaní, obkladov, švov, rámov z plastových okien, betónových povrchov. Činidlo sa aplikuje na infikovanú oblasť po 20 minútach a premyje sa vodou. Rýchlo bojuje proti škvrnám od plesní, zabraňuje ich vzhľadu a šíreniu. Stojí to 260 p. na 750 ml.
- Sprejový fungicíd "Titan". Používa sa na odstránenie huby z drevených, natretých alebo poréznych povrchov. Nie je potrebné predformovať, produkt sa rozprašuje zo vzdialenosti 10 cm a po 20 minútach sa umyje vodou. Obsahuje chlór, preto sa musí používať opatrne a po ošetrení vetrať miestnosť. Stojí to 197 s. na 500 ml.
- Koncentrovaná pleseň Belinka. Musí sa zriediť vodou v pomere 1: 4. Povrch je ošetrený kefou. Nechá sa zaschnúť 12 hodín, potom sa oblasť očistí od mŕtvych húb špachtľou alebo horúcou vodou. Počas manipulácie by ste mali nosiť ochranný odev a respirátor. Stojí to 345 s. na 1 liter
Ľudové lieky
Osvedčené výrobky na kontrolu plesní sa nachádzajú v každej domácnosti. Alternatívne metódy môžu byť účinné v malých kolóniách húb alebo pri ich lokalizácii na domácich výrobkoch. Zjavnou výhodou domácich liekov je neškodnosť pre ľudí, lacnosť.
Stolový ocot, sóda, peroxid vodíka, alkohol, bežné bielidlo dokonale odstráni pleseň, zabráni jej opätovnému vzhľadu.
Z plesne v práčke

Huba môže zasiahnuť práčku pri umývaní pri nízkych teplotách as použitím aviváže. Forma sa usadí v plastových vaničkách na prášok a kondicionér, v záhyboch gumového tesnenia bubna stroja. Aby ste sa zbavili huby a prekonali nepríjemný zápach, vyčistite vnútorné prvky, môžete použiť osvedčené metódy:
-
Kyselina citrónová Nalejte 300 g citróna do bubna práčky, zapnite najkratšie pranie bez bielizne. Huba sa bojí kyslého prostredia a zomiera. Po ukončení cyklu vysušte bubon a podnosy.
- Bielu. Čistí všetky časti stroja, aby žiaril, eliminuje zatuchlaný zápach. Nalejte 1 liter produktu do misiek na prášok a kondicionér. Zapnite najdlhší režim prania s najvyššou teplotou. Keď sa voda zohreje, pranie zastavte, aby mohol pôsobiť chlór. Trvá to niekoľko hodín. Potom pokračujte v umývaní. Na konci procesu vysušte bubon a podnosy. Pri používaní bielidla dodržiavajte bezpečnostné opatrenia, používajte gumové rukavice.
Na stenách

Čierna pleseň v dome alebo byte je vytvorená s vysokou vlhkosťou a zlou cirkuláciou - hlavne v kúpeľni alebo kuchyni. Chybné vetranie, zriedkavé vetranie, plastové okná často spôsobujú jeho formovanie.
Čierna pleseň na stenách, v rohoch bytu sa môže vyskytnúť pri silnom zamrznutí.
Aby ste odstránili nebezpečného parazita, porazte ho úplne, existuje niekoľko efektívnych spôsobov, ako doma:
-
Borax. Prášok zrieďte vodou 1:10, naneste kefou alebo kefou na stenu, vysušte. Tento nástroj neutralizuje pleseň a bojuje s ňou bez toho, aby mal škodlivý vplyv na ľudské zdravie.
- Peroxid vodíka. Pomocou rozprašovacej pištole naneste na infikovanú oblasť 3% roztok lieku, počkajte 10 minút, mechanicky očistite vrstvu formy.
- Síran meďnatý. 100 g prášku sa zriedi v 10 1 vody. Výsledným roztokom ošetrite postihnuté miesta steny, suché. Nevýhodou tohto spôsobu je modrý povlak na ošetrenom povrchu.
V chladničke

Vlhkosť, zlé vetranie alebo nedostatočné vetranie v chladničke sú dobrými podmienkami pre rast huby. Ak sa na palete alebo vo výpustnom otvore vyskytnú škvrny, musia sa prijať neodkladné opatrenia:
-
Soda. Liek na čiernu pleseň dokonale čistí zubný povlak a je neškodný pre človeka.Položte sódu prášok na vlhkú handru alebo špongiu, umyte vnútro chladničky, utrite čistou navlhčenou textíliou, vysušte kameru, vetrajte.
- Čajový olej. Silné antiseptikum má príjemnú vôňu. Dokonalým bojom proti húb v chladničke je roztok tohto oleja s vodou - 1 čajová lyžička na 1 pohár vody. Utrite textíliou navlhčenou v chladiacom priestore, odkvapkávacej miske a výpustnom otvore. Opláchnutie vodou nie je potrebné. Po ošetrení vetrajte.
Na tmel v kúpeľni

Jedným z obľúbených miest na objavenie sa plesní je tesniaci prostriedok v kúpeľni. Konštantná vlhkosť, teplý vzduch, nedostatočné vetranie vyvolávajú v mrazenom poréznom silikóne vzhľad plesne. Na čistenie tmelu sú vhodné:
-
Bleach. Produkt účinne odstraňuje plesne, dezinfikuje a vracia jasne bielu farbu na silikón. Najskôr dobre umyte švy teplou mydlovou vodou, opláchnite vodou a utrite handrou. Po nanesení bielidla 12-15 minút utrite kefou, opláchnite veľkým množstvom vody.
- Ak sa huba dostane pod silikónovú vrstvu, odstráňte ju rezom ostrým nožom pozdĺž okraja. Vyčistite všetky nečistoty zo spoja. Dezinfikujte izopropylalkoholom. Vysušte, nechajte jeden deň a potom vyplňte novú vrstvu hygienického tmelu určenú pre kúpeľne.
Na tkanine

Pri skladovaní v teplej a vlhkej miestnosti sa na tkaninách môžu objaviť škvrny od plesní. Prvá vec, ktorú musíte zničiť a zbaviť sa, je vydržať a dobre usušiť veci na slnku. Potom môžete pristúpiť k liečbe ľudových liekov:
-
Citrónová šťava alebo ocot. Utierku dôkladne navlhčite a nechajte uschnúť. Potom umyte pridaním kyseliny citrónovej do pracieho prostriedku.
- Peroxid vodíka. Silne navlhčite škvrnu, nechajte ju hodinu, umývajte ju v intenzívnom režime v práčke.

